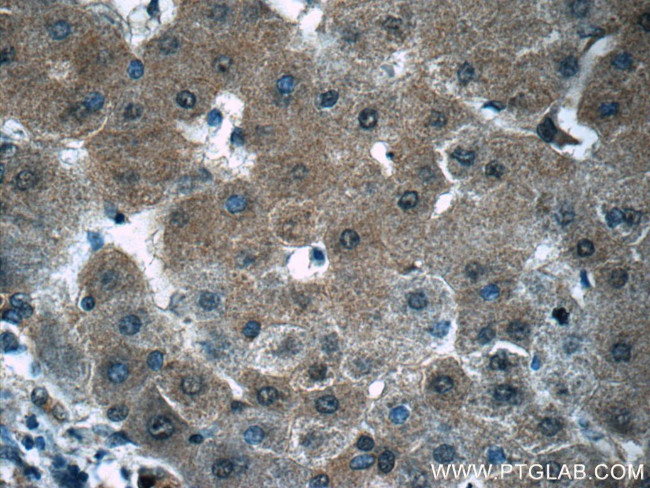
PGK1 Antibody in Immunohistochemistry (Paraffin) (IHC (P))

Search
Proteintech
PGK1 Polyclonal Antibody
{{$productOrderCtrl.translations['antibody.pdp.commerceCard.promotion.promotions']}}
{{$productOrderCtrl.translations['antibody.pdp.commerceCard.promotion.viewpromo']}}
{{$productOrderCtrl.translations['antibody.pdp.commerceCard.promotion.promocode']}}: {{promo.promoCode}} {{promo.promoTitle}} {{promo.promoDescription}}. {{$productOrderCtrl.translations['antibody.pdp.commerceCard.promotion.learnmore']}}
产品信息
17811-1-AP
种属反应
已发表种属
宿主/亚型
分类
类型
抗原
偶联物
形式
浓度
规格
纯化类型
保存液
内含物
保存条件
运输条件
产品详细信息
Immunogen sequence: MSLSNKLTL DKLDVKGKRV VMRVDFNVPM KNNQITNNQR IKAAVPSIKF CLDNGAKSVV LMSHLGRPDG VPMPDKYSLE PVAVELKSLL GKDVLFLKDC VGPEVEKACA NPAAGSVILL ENLRFHVEEE GKGKDASGNK VKAEPAKIEA FRASLSKLGD VYVNDAFGTA HRAHSSMVGV NLPQKAGGFL MKKELNYFAK ALESPERPFL AILGGAKVAD KIQLINNMLD KVNEMIIGGG MAFTFLKVLN NMEIGTSLFD EEGAKIVKDL MSKAEKNGVK ITLPVDFVTA DKFDENAKTG QATVASGIPA GWMGLDCGPE SSKKYAEAVT RAKQIVWNGP VGVFEWEAFA RGTKALMDEV VKATSRGCIT IIGGGDTATC CAKWNTEDKV SHVSTGGGAS LELLEGKVLP GVDALSNI (1-417 aa encoded by BC103752)
靶标信息
Also known as ATP:3-phosphoglycerate 1-phosphotransferase showed that the plasmin reductase isolated from conditioned medium of fibrosarcoma cells is the glycolytic enzyme phosphoglycerate kinase. They concluded that phosphoglycerate kinase not only functions in glycolysis but is secreted by tumor cells and participates in the angiogenic process as a disulfide reductase.
仅用于科研。不用于诊断过程。未经明确授权不得转售。
生物信息学
蛋白别名: Cell migration-inducing gene 10 protein; epididymis secretory sperm binding protein Li 68p; MIG10; PGK1; Phosphoglycerate kinase 1; Primer recognition protein 2; PRP 2; unnamed protein product
基因别名: HEL-S-68p; MIG10; OK/SW-cl.110; Pgk; Pgk-1; PGK1; PGKA
UniProt ID: (Human) P00558, (Mouse) P09411, (Rat) P16617
Entrez Gene ID: (Human) 5230, (Mouse) 18655, (Rat) 24644